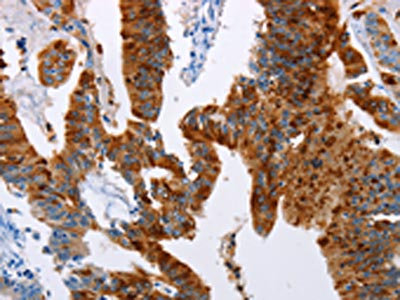

TFF3 Antibody
-
中文名稱:TFF3兔多克隆抗體
-
貨號:CSB-PA038921
-
規格:¥1100
-
圖片:
-
其他:
產品詳情
-
Uniprot No.:
-
基因名:TFF3
-
別名:hITF antibody; hP1.B antibody; Intestinal trefoil factor antibody; ITF antibody; mITF antibody; OTTMUSP00000021729 antibody; P1B antibody; Polypeptide P1.B antibody; TFF3 antibody; TFF3_HUMAN antibody; TFI antibody; TREFOIL antibody; Trefoil factor (intestinal) antibody; Trefoil factor 3 antibody
-
宿主:Rabbit
-
反應種屬:Human
-
免疫原:Fusion protein of Human TFF3
-
免疫原種屬:Homo sapiens (Human)
-
標記方式:Non-conjugated
-
抗體亞型:IgG
-
純化方式:Antigen affinity purification
-
濃度:It differs from different batches. Please contact us to confirm it.
-
保存緩沖液:-20°C, pH7.4 PBS, 0.05% NaN3, 40% Glycerol
-
產品提供形式:Liquid
-
應用范圍:ELISA,IHC
-
推薦稀釋比:
Application Recommended Dilution ELISA 1:2000-1:5000 IHC 1:50-1:200 -
Protocols:
-
儲存條件:Upon receipt, store at -20°C or -80°C. Avoid repeated freeze.
-
貨期:Basically, we can dispatch the products out in 1-3 working days after receiving your orders. Delivery time maybe differs from different purchasing way or location, please kindly consult your local distributors for specific delivery time.
-
用途:For Research Use Only. Not for use in diagnostic or therapeutic procedures.
相關產品
靶點詳情
-
功能:Involved in the maintenance and repair of the intestinal mucosa. Promotes the mobility of epithelial cells in healing processes (motogen).
-
基因功能參考文獻:
- TFF3 located in the renal tubular epithelial cells may play a role in the progression of tubulointerstitial fibrosis in IgA nephropathy patients. PMID: 29987860
- Authors hypothesised that TFF3 may involve regulatory networks of ncRNAs to exert its effects as a scattering factor. PMID: 28277538
- The highly specific expression of TFF3 in mucinous ovarian cancer may help to further clarify potential relationships of tumors with mucinous histology PMID: 28470574
- This is, to our knowledge, the first report of decreased expression of TFF3, SPDEF, KLF4, and goblet cell population in the colon of patients with HSCR. Altered goblet cell function may result in intestinal barrier dysfunction contributing to the development of HAEC. PMID: 29383490
- High TFF3 expression is associated with oncogenicity and chemoresistance in hepatocellular carcinoma. PMID: 28445151
- Results indicate diagnostic biomarker potential of Trefoil factor 3 (TFF3) promoter hypomethylation for prostate cancer (PC) as well as prognostic biomarker potential of TFF3 RNA expression. PMID: 28930171
- ITF role in promoting intestinal epithelial cells migration through crosstalk between the ERK and JAK/STAT3 pathways PMID: 27616044
- TFF3 levels were significantly elevated in patients with stage I (p= 0.001) and T1 gastric cancer (p= 0.013). PMID: 28453457
- The present study demonstrated a negative association between the expression of miR75p and TFF3 in IBD lesional tissues and normal tissues. In conclusion, TFF3 was identified as a novel target of miR75p PMID: 28627600
- trefoil factors family 3 may have a role in colorectal cancer PMID: 28405143
- This study provides the first evidence that TFF3 is locally elevated in the peritoneal cavity in endometriosis and might play a role in disease pathogenesis and its associated inflammatory processes. Furthermore, the results show that TFF3 is regulated through the menstrual cycle. PMID: 27330011
- involvement of TFF3 in the pathogenesis of rhonchopathy and OSA PMID: 29028798
- Giardia co-infection promotes the secretion of antimicrobial peptides beta-defensin 2 and trefoil factor 3 and attenuates attaching and effacing bacteria-induced intestinal disease.( PMID: 28622393
- expression reduces growth, viability, and tumorigenicity of retinoblastoma cell oines PMID: 27626280
- The expression of TFF3 and TWIST1 might be associated with the survival of patients with colorectal cancer (CRC) after curative resection and might be pivotal predictors of disease progression. TFF3 may be correlated to the invasiveness of CRC. PMID: 28104986
- Serum TFF-3 is not a convenient and reliable surrogate marker of mucosal healing during therapy with TNF-alpha antagonists in Crohn's disease. PMID: 28104989
- TFF3 levels differed among idiopathic pulmonary fibrosis, pulmonary sarcoidosis and chronic pulmonary obstructive disease. PMID: 27758987
- TFF3 protein knockout can facilitate apoptosis of human pituitary adenoma HP75 cells via mitochondrial pathway PMID: 26823779
- Data show that trefoil factor-3 (TFF3) secreted from mammary carcinoma cells promotes de novo angiogenesis via interleukin-8 (IL-8)/IL-8 receptor CXCR2. PMID: 26559818
- Dimers CXCR4 and CXCR7 are involved in TFF3-dependent activation of cell migration, but not cell proliferation. The ERK1/2 pathway is activated in the process, but not influenced by CXCR4 or CXCR7. PMID: 26780310
- TFF3 expression is associated with response to endocrine therapy, and outperforms oestrogen receptor, progesterone receptor and TFF1 as an independent biomarker, possibly because it mediates the malign effects of oestrogen on invasion and metastasis PMID: 25900183
- the results provide a mechanistic explanation for ITF-mediated protection of gastric epithelial mucosa cells, suggesting that activation of the ERK1/2 signaling pathway may provide a new therapeutic strategy for repairing gastric injury. PMID: 25776570
- primary outcome measures were to evaluate the safety, acceptability, and accuracy of the Cytosponge-TFF3 test compared with endoscopy and biopsy. In all, 1,042 (93.9%) patients successfully swallowed the Cytosponge, and there were no serious side effects PMID: 25634542
- TFF3 is not only a useful biomarker for a long-term surgical result in CRC patient, but also may be a risk factor of early recurrence. PMID: 25405728
- Associations discovered between trefoil factor 3 gene variants and idiopathic recurrent spontaneous abortion. PMID: 25444508
- TFF3 expression predicts metastasis and poor survival outcome of patients with mammary carcinoma. PMID: 25266665
- TFF3 expression may be absent in the early stages of Barrett's esophagus and its expression may represent more established columnar epithelium. PMID: 25424203
- This study suggests that TFF3 is an independent indicator for survival in GC, while HER2 is not associated with the outcome. Patients with HER2-negative/TFF3-negative GC have the best outcome. PMID: 25514872
- High TFF3 expression is associated with reduces sensitivity to ionising radiation in prostate carcinoma. PMID: 25748388
- Study supports the notion that ITF can promote cell proliferation, migration and preserve epithelium integrity. PMID: 24990304
- LRP2 sequencing reveals multiple rare variants associated with urinary trefoil factor-3 PMID: 24876117
- Serum concentrations of TFF3 is significantly higher in chronic kidney disease. PMID: 24282531
- TFF3 expression at both mRNA and protein levels was significantly downregulated by ErbB-2 silencing in breast cancer cell lines PMID: 24164280
- A significantly higher trefoil factor 3 expression in luminal epithelial cells was detected in women with unexplained infertility PMID: 24228773
- TFF3 point mutations seem to be a rare event in colorectal carcinogenesis; TFF3 expression may play a role in promoting lymph node metastases of CRCs. PMID: 24125969
- TFF3 is an independent indicator for overall survival in gastric cancer. PMID: 23822993
- In serum TFFs and pepsinogen tests, only serum TFF3s were not significantly affected by H. pylori eradication, suggesting that serum TFF3 could be a stable biomarker of gastric cancer risk even after H.pylori eradication PMID: 22907485
- TFF3 hypermethylation is associated with triple-negative breast cancers. PMID: 24045095
- interaction between DMBT1(gp340) and trefoil TFFs proteins was investigated using an ELISA assay. DMBT1(gp340) bound to solid-phase bound recombinant dimeric TFF3 in a calcium dependent manner PMID: 23691218
- ER+ /PR+ /TFF3+ /IMP3- immunoprofile distinguishes endometrioid from serous and clear cell carcinomas of the endometrium. PMID: 23570281
- Using a Caco-2 cell model the study showed that TLR2 and TFF3 inhibit the IL-1beta induced increase in permeability and release of proinflammatory cytokines, and that this effect is mediated by activation of PI3K/Akt signaling. PMID: 24051092
- Distinct ERG and TFF3 protein was expressed in 45% (43/96) and 36% (35/96) of prostate cancers, respectively. PMID: 23856515
- Our study suggests that Twist, as an important potential downstream effector, plays a key role in TFF3-modulated metastasis in gastric cancer and can be a promising therapeutic target against intestinal-type gastric cancer. PMID: 23845905
- TFF3 activated the epithelial cells in culture to produce beta defensins 2 (hBD2) and beta defensins 4 PMID: 23198942
- TFF3 seems to be a novel pathway in the pathogenesis of type I endometrial carcinomas. PMID: 23578537
- Upregulation of TFF3 after chemoradiotherapy for rectal cancer is associated with a higher risk of relapse. The physiological role of TFF3 in restoring the mucosa during CRT could be interfering with treatment efficacy. PMID: 22516806
- Measurement of TFF3 mRNA in aspirates from thyroid nodules using mesh filtration. PMID: 22572548
- TFF3 may contribute to ocular surface wound healing after Amniotic membrane transplantation, but its production by AM is not further inducible by proinflammatory stimuli. PMID: 22476621
- Report TFF3 expression in normal/diseased pancreas. PMID: 22286382
- Differential expression of MUC5AC involves crosstalk between interleukin-1beta and Akt, whereby the trefoil factor family peptide TFF3 activates Akt by phosphorylation of EGFR. PMID: 22389405
顯示更多
收起更多
-
亞細胞定位:Secreted, extracellular space, extracellular matrix. Cytoplasm.
-
組織特異性:Expressed in goblet cells of the intestines and colon (at protein level). Expressed by goblet cells of small and large intestinal epithelia and also by the uterus. Also expressed in the hypothalamus where it is detected in paraventricular, periventricular
-
數據庫鏈接:
Most popular with customers
-
-
YWHAB Recombinant Monoclonal Antibody
Applications: ELISA, WB, IHC, IF, FC
Species Reactivity: Human, Mouse, Rat
-
-
-
-
-
-